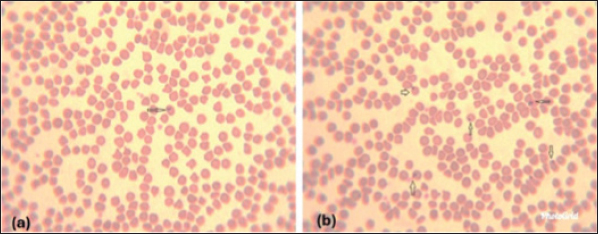

| Research Article | ||
Open Vet. J.. 2025; 15(6): 2823-2830 Open Veterinary Journal, (2025), Vol. 15(6): 2823-2830 Research Article Molecular diagnosis of hemoplasma infection in cats and sheep with hematological studiesSahar E. Ouda1*, Randa A. Hassan2, Eissa S. Ismaeel1, Rania Abo Sakaya3*, Emad Beshir Ata4, Doaa Sedky4, Mai M. Kandil5 and Laila M. El shabiny11Department of Mycoplasma, Animal Health Research Institute, Agricultural Research Center (ARC), Giza, Egypt 2Department of Pathology, Animal Health Research Institute, Agricultural Research Center (ARC), Giza, Egypt 3Department of Animal Medicine, Faculty of Veterinary Medicine, Benha University Moshtohor, Toukh, Egypt 4Department of Parasitology and Animal Diseases, Veterinary Research Institute, National Research Centre, Giza, Egypt 5Department of Microbiology and Immunology, Veterinary Research Institute, National Research Centre, Cairo, Egypt *Correspondence to: Sahar E. Ouda. Department of Mycoplasma, Animal Health Research Institute, Agricultural Research Center (ARC), Giza, Egypt. Email: seoa200 [at] yahoo.com and Rania Abo-Sakaya. Department of Animal Medicine, Faculty of Veterinary Medicine, Benha University Moshtohor, Toukh, Egypt. Email: rania.aboskayah [at] fvtm.bu.edu.eg Submitted: 25/04/2025 Revised: 13/05/2025 Accepted: 13/05/2025 Published: 30/06/2025 © 2025 Open Veterinary Journal
AbstractBackground: Diagnosis of hemoplasma infections is currently based on microscopical examination of blood smears, together with the results of specific polymerase chain reaction (PCR) assays. Aim: In the present study, molecular detection using 16S rRNA was used as a diagnostic approach for detection and genetic characterization of the hemoplasma in cats and sheep. However, hematological studies were applied to sheep showing emaciation. Methods: In the present study, blood smears examination, hemogram, blood cells count, and molecular detection using 16S rRNA were used as a diagnostic approach for the detection and genetic characterization of the hemoplasma in cats and sheep. Results: We found that hemoplasma incidence in cats in the examined samples was 8%, and Candidatus M. haemominutum was detected at 202 bp band size by 16SrRNA and Candidatus M. haemovis in sheep. The infection rate in the examined sheep was 4% (2/50) by nested PCR giving specific bands at 1,060 and 506 bp. Giemsa-stained blood smear from an affected sheep with hemoplasma showed a small oval to ring-shaped organism noticed on the surface of erythrocytes. The organisms have other variable shape (cocci, small rods are arranged in short chains) with the presence of free organisms in the background of blood smear. Haemovis are epicellular parasites which attached in the indentation and invagination of the erythrocyte surface causing the direct injury of red blood cells. Poikilocytosis was very obvious. Abnormal features of red corpuscles were noticed as pointy or thorn-like projections. Destruction of erythrocytes causes anemia; these features led to a significant decrease in total erythrocyte count, and polychromasia was noticed. Moreover; neutrophils with foamy and opaque cytoplasm were observed. The leucogram showed leucopenia due to lymphocytopenia while, neutrophils rose, monocytes, and eosinophils showed an elevation level. Conclusion: This is the first microscopical and molecular identification of haemovis in sheep in Giza, Egypt. Further investigation is recommended for epidemiology and control measures of haemotropic mycoplasma. Keywords: Hemoplasma, Haemovis, CMhm, Hematological studies. IntroductionFarm animals play an important role in maintaining global food (Ge et al., 2024; Shalaby et al., 2024; Al-Ebshahy et al., 2025). They were subjected to different pathogens that affect their productivity (Ibrahiem et al., 2023; Ata et al., 2024; Kasem et al., 2024; El-gbily et al., 2025). Heamotropic mycoplasmas (HM) are small red blood cell (RBC) parasites that attach to the RBC resulting in erythrocytic deformity and damage (Arendt et al., 2024). In animals, disease manifestations due to HM infection are commonly reported in association with drug-or virus-induced immunosuppression, with stressors such as poor nutrition, pregnancy, or lactation, or with concurrent infection with other more virulent pathogens (Tanahara et al., 2010). Because of the haemato-tropic nature, the infection results in anemia, weakness, paler mucous membranes, and tachypnea, in a wide range of animals (Tasker, 2020). However, infection in sheep causes anemia, fever, anorexia, and lymphadenopathy (Song et al., 2014). The pathogen was found to be transmitted mainly by blood-sucking insects, but other routes were also recorded either by blood transfusion or transpalcental (de Souza Ferreira et al., 2024). Previously, the accurate laboratory diagnosis of hemoplasma infections was generally impaired by the insufficient sensitivity and specificity of the microscopic examination in blood-stained smears. All attempts to isolate and culture HM have failed, so the analysis of biological features and pathogenesis of the bacteria was limited (Kmetiuk et al., 2025). The development of molecular methods shared in the accurate diagnosis of multiple pathogens (Ata et al., 2021; Salman et al., 2024), in particular polymerase chain reaction (PCR) amplification based on the 16SrDNA gene, has greatly facilitated the molecular characterization of these causative agents. This diagnostic approach has resulted in the discovery of several novel hemoplasmas species in different hosts (Willi et al., 2006; Hoelzle et al., 2011). The first molecular evidence of the occurrence of “Candidatus M. haemovis” in sheep and goats was reported in China (Wang et al., 2017). At the national level first molecular evidence of the occurrence of hemoplasma in different animals as in cats Candidatus M. haemominutum (CMhm) and “Candidatus M. haemovis” in sheep and goats in Egypt was in 2024 (Eissa et al., 2024). In the present study, blood smears examination, hemogram, blood cells count, and molecular detection using 16S rRNA were used as a diagnostic approach for detection and genetic characterization of the hemoplasma in cats and sheep. Material and MethodsEthical approvalThis research was done under the approval of the Institutional Animal Care and Use Committee (ARC-IACUC) of the Agricultural Research Center, with the IACUC Protocol Number: ARC AHRI 23 32 AnimalsStudied animals were admitted from different localities of Giza governorate; Egypt, to the Animal Health Research Institute (AHRI) showing signs of anemia and emaciation or apparently healthy. Blood sample collectionHundred blood samples were collected on dipotassium Ethylene-Diamine Tetra Acetic Acid as an anticoagulant from the jugular veins of 50 sheep and from the caudal veins of 50 cats. The collected samples were stored in a cooler box and transported to the Mycoplasma department (AHRI main branch) for molecular diagnosis of hemoplasma and Pathology department (AHRI main branch) to determine parameters of hemograme which include erythrocyte count (RBCs), total and differential leucocyte counts using Exigo Veterinary Hematology analyzer with serial No. 5169, and software version 2.7.6, manufactured by Boule Medical A B, Sweden. Extraction of DNAThe total genomic DNA was extracted from blood samples using GF-1 Blood DNA Extraction kit (VIVANTIS) Cod.no.GF-BD-100 (Malezia). The quality and concentration of the eluted DNA were assessed using spectrophotometer. Molecular detectionThe following primers were used for molecular identification of hemoplasma in cats. The following primers were used according to Tanahara et al. (2010) with modifications: F-5′ ATGCCCTCTGTGGGGGATAGCCG 3′ Mycoplasma haemofelis Common R-5′ATGGTATTGCTCCATCAGACTTTCG 3′ reverse primer CMhm F-5′ CTGGGAAACTAGAGCTTCGCGAGC 3′ specific forward (CMhm primer). 2-Primer used for Candidatus M. turicensis primer: CMt F-5′AGAGGCGAAGGCGAAAACT3′ R-5′CTACAACGCCGAAACACAAA 3′ The PCR thermal program included initial denaturation at 94°C for 5 minutes, 35 cycles of denaturation at 94°C for 45 seconds, annealing using a temperature gradient (56°C for 45 seconds), and polymerization (72°C for 45 seconds). 3-Nested PCR for hemoplasma of sheep according to Wang et al. (2017): The following primers were used for the detection of hemoplasma in sheep, 1st PCR primer sets: A1 5′GGATAGCAGCCCGAAAGG 3′ and A2 5′ GCAGCCCAAGGCATAAGG 3′ B1 5′CTACGGGAAGCAGCAGTG3′ and B2 5′ CTCGACCTAACATCAAATAC CT3′ Amplification procedures: First round PCR was performed as follows, 94°C for 5 minutes, then 30 cycles of 94°C for 30 seconds, 61°C for 30 seconds, and 72°C for 1 minute, with a final step of extension at 72° for 7 minutes, followed by a second round of nested PCR at 94°C for 5 minutes, then 35 cycles of 94°C for 30 seconds, 59°C for 30 seconds, and 72°C for 45 seconds, with a final extension step at 72°C for 7 minutes. ResultsHematological resultsTable 1 illustrates changes in hemogram of sheep infected with haemovis. The erythrogram showed a significant decrease in total erythrocyte count and polychromasia was noticed. Also, the leucogram demonstrated the presence of leucopenia due to lymphocytopenia while neutrophils rose, also, monocytes, and eosinophils showed elevation. Table 1. Illustrated changes in hemogram of sheep infected with haemovis.
Giemsa-stained blood smear from an affected sheep with hemoplasma showed a small oval to ring-shaped organism noticed on the surface of erythrocytes (Fig. 1a and b). The organisms have other variable shape (cocci, small rods are arranged in short chains) blood smears showing erythrocytes injured by hemoplasma (Fig. 2b and c). Furthermore, the presence of free organisms in the background of blood smear (Fig. 3a) and abnormal features of red corpuscles was noticed as pointy or thorn-like projections (Fig. 3b and c). However, an activated neutrophil with foamy and opaque cytoplasm was recorded (Fig. 3d).
Fig. 1. (a, b) Blood smears showing different forms of hemoplasma attached to the surface of erythrocytes (arrows) (Wright, Giemsa stain).
Fig. 2. (a) Blood smear showing stages of affected RBCs with hemoplasma, often, respectively (Wright, Giemsa stain). (b, c): blood smears showing erythrocytes injured by hemoplasma (Wright, Giemsa stain).
Fig. 3. (a) Blood smear showing deformation of many erythrocytes (Wright, Giemsa stain). (b, c): blood smears showing abnormal erythrocytes with features of poikilocytosis; pointy or thorn-like projections (destructed erythrocytes, anemia) (Wright, Giemsa stain). (d): blood showing activated neutrophil with foamy and opaque cytoplasm (Wright, Giemsa stain). Molecular detection of hemoplasma in catsIn the present study, different primers were used to detect Feline hemoplasmas including M. haemofelis, M. turicensis and M. haemominutum, we found that only CMhm was detected with an incidence of 8% (4/50) at position 202 bp by 16SrRNA (Fig. 4).
Fig. 4. Lane 1:100 bp DNA ladder; lanes 2 control positive (OQ565624) for CMhm; lane 3: control negative; lanes 4-7: positive samples for CMhm of cat at 202 bp. Molecular detection of Candidatus M. haemovis in sheepBlood samples from sheep from the Giza governorate were collected during October –December 2024. The infection rate in sheep was 4% (2/50) by nested PCR giving specific bands at 1,060 bp and 50 6bp (Figs. 5 and 6).
Fig. 5. PCR for sheep at 1,060 bp; Lane M: 100 bp ladder, lanes 1–3 and 5,6,8,9 negative samples for haemovis. Lane C-:control negative ; Lane C+: M. ovis positive strain (OQ310852); lane 4 &7: positive sheep samples at 1,060 bp.
Fig. 6. Nested PCR for sheep samples at 506 bp; M: 100 bp ladder, lanes 1: Control negative. Lane 2: M. Haemovis positive strain OQ310852; lane 3 & 7: positive sheep samples at 506 bp; Lanes 4–6: Negative sheep samples. DiscussionHaemotropic mycoplasmas or hemoplasmas is a term including a group of small bacteria known as Haemobartonella or Eperythrozoon spp. which lack a cell wall that infects the erythrocytes of laboratory, domestic, and wild animals (Alabí et al., 2020). Infections caused by hemoplasmas can lead to a range of conditions, from severe hemolytic anemia that can be life-threatening to more subtle issues such as chronic anemia, poor growth, and infertility. Furthermore, these organisms may also contribute to the worsening of retroviral infections, tumors, and immune-mediated disorders. The close interaction between hemoplasma organisms and RBCs results in cellular damage through immune-mediated responses and other mechanisms that remain unclear. Even with a strong immune reaction and antibiotic treatment, infected animals likely become chronic carriers after their clinical symptoms have subsided (Messick, 2004). Our investigation revealed the presence of multiple stages of direct affected erythrocytes by hemoplasma (haemovis) beginning with the attachment of organism to RBC surfaces and then through residing in indentation and invagination, distortion of red blood corpuscle until reaches complete injury. More than 10% of erythrocytes become abnormally shaped (poikilocytosis) accompanied by intravascular hemolysis and in addition to extravascular inducing hemolytic anemia. In this study, polychromasia and immature RBCs were noticed in peripheral blood smear. Usually, it is a sign that erythrocytes are being destroyed quickly than body can replace them (hemolytic anemia) (Coles, 1986; Suzuki et al., 2011). Leukogram in this study showed leucopenia due to lymphocytopenia while, neutrophils rose, also, monocytes and eosinophils showed elevation. In our study, the differential leucocytic count revealed a small number of activated neutrophils with foamy opaque cytoplasm indicating the bacterial infection (Coles, 1986). Suzuki et al. (2011) mentioned that variations in the hematological values might be attributed to infection stages rather than differences in the hemoplasma strains, which were almost identical in the 16S rRNA sequences as confirmed by Eissa et al. (2024). Zachary (2017) reported that the effects of hemoplasma infection varied from subclinical to fatal anemia depending on host susceptibility, specific organism and dose. Intravascular hemolysis occurs, but anemia mainly is due to extravascular hemolysis. Although incomplete understanding of the pathogenic mechanisms but immune-mediated component is highly probable. Haemotropic mycoplasma induces unclear cold agglutination in infected individuals. These particular antibodies play an important role in the development of hemolytic anemia. According to the duration of hemolysis, there are varying degrees of erythroid hyperplasia in bone marrow. However, the red pulp of the spleen suffers from macrophage hyperplasia and erythrophagocytosis accompanied by increased plasma cell number as microscopical lesions during the acute hemoplasma infection. It is worth noting that although hemoplasma infection could occur in ovine species, clinical signs recorded in goats were milder than those of sheep (Stuen, 2016). Multiple approaches were found to be used for the diagnosis of hemoplasma infection including microscopic examination. But, molecular detection was recorded to be the most sensitive tool for accurate diagnosis (Hampel et al., 2014), especially this pathogen could not be cultivated and microscopic detection lacks specificity and sensitivity, and recommendation for only molecular studies should be considered (Arendt et al., 2024). Accordingly, the molecular approach was used for the diagnosis of the tested samples. Although felines were previously recorded by multiple hemoplasmas, based on the results obtained, only M. haemominutum was detected with a ratio of (8%). A variable range of infections from (9% to 16%) was recorded in European countries (Ravagnan et al., 2017; Díaz-Regañón et al., 2018). A higher rate was recorded in Thailand as the total infection of (38.05%) was positive for hemoplasma and 83.33% were infected with CMhm, while 13.33% were infected with M. haemofelis, and 3.33% with Candidatus Mycoplasma turicensis (Do et al., 2020). Interestingly, a recently published study about the infection rate in the same area was higher (20%) of CMhm but also, the M. haemofelis was not detected (Eissa et al., 2024). It is worth to clear that fighting between cats was an important route for transmission of this pathogen between this animal species (Moore et al., 2024). A lower infection rate (4%) was determined in the examined blood samples of sheep. A similar rate (6%) was determined in Tunisia (Rjeibi et al., 2015). However, a higher infection rate (39.3%) was recorded in Brazilian goats (Machado et al., 2017). The highest extreme rate was found in 69% to 76% in the USA (Urie et al., 2019) and in Brazil (79%) (Souza et al., 2019). Infection in young age could lead to severe hemolytic anemia (Paul et al., 2020). While, in older ones, the infection rate is mostly chronic with less clinical signs but it greatly reflects on the animal productivity (Tagawa et al., 2012). In conclusion, this is the first microscopical and molecular identification of haemovis in sheep in Giza, Egypt. Further investigation is recommended for epidemiology and control measures of haemotropic mycoplasma. AcknowledgmentsNone. Conflict of interestThe authors declare that there is no conflict of interest. FundingThis research received no specific grant. Authors’ contributionsThe authors contributed equally to this work. Data availabilityAll data supporting the findings of this study are available within the manuscript. ReferencesAlabí, A.S., Monti, G., Otth, C., Sepulveda-García, P., Sánchez-Hidalgo, M., de Mello, V.V.C., Machado, R.Z., André, M.R., Bittencourt, P. and Müller, A. 2020. Molecular survey and genetic diversity of hemoplasmas in rodents from Chile. Microorganisms 8, 1493; doi:10.3390/microorganisms8101493 Al-Ebshahy, E.M., AboElkhair, M., Amer, S., Salama, A., Nayel, M., Abbas, R., Hamza, H., Abas, O. and Ata, E.B., 2025. A study for molecular detection of co-circulated multiple FMDV serotypes in some Egyptian governorates. Egypt. J. Vet. Sci. 51, 1–10; doi:10.21608/ejvs.2024.337086.2501 Arendt, M., Stadler, J., Ritzmann, M., Ade, J., Hoelzle, K. and Hoelzle, L.E. 2024. Hemotrophic mycoplasmas— vector transmission in livestock. Microorganisms 12, 1278; doi:10.3390/microorganisms12071278 Ata, E.B., Abdel-Aziz, T.H., Abdel-Ghany, H.S.M., Elsawy, B.S.M., Abdullah, H.H.A.M., Abouelsoued, D., Ashry, H.M., Hassan, M.R., Shapaan, R.M., Nasr, S.M., Mahmoud, M.S., Abdel Megeed, K.N. and Abdel-Shafy, S. 2024. Molecular and serological diagnosis of the circulating Trypanosoma evansi in Egyptian livestock with risk factors assessment. Microb. Pathog. 197, 107073; doi:10.1016/j. micpath.2024.107073 Ata, E.B., Allam, A.M., Elbayoumy, M.K. and Mahmoud, M.A.E.-F. 2021. Electron microscopy and phylogenetic analysis of Bovine papillomavirus infection in cattle from four Egyptian governorates. Trop. Anim. Health Prod. 53, 160; doi:10.1007/s11250-021-02607-4 Coles, E.H. 1986. Veterinary clinical pathology, 4th ed. Philadelphia, PA: W. B. Saunders Company. de Souza Ferreira, L., Bolin, S., Abuelo, A., Norby, B. and Ruegg, P.L. 2024. Apparent prevalence of transplacental transmission of hemotropic mycoplasmas in Holstein dairy calves. JDS Commun. 5, 587–591; doi:10.3168/jdsc.2023-0518 Díaz-Regañón, D., Villaescusa, A., Ayllón, T., Rodríguez-Franco, F., García-Sancho, M., Agulla, B. and Sainz, Á. 2018. Epidemiological study of hemotropic mycoplasmas (hemoplasmas) in cats from central Spain. Parasit. Vectors 11, 140; doi:10.1186/s13071-018-2740-9 Do, T., Kamyingkird, K., Bui, L.K. and Inpankaew, T. 2020. Genetic characterization and risk factors for feline hemoplasma infection in semi-domesticated cats in Bangkok, Thailand. Vet. World 13, 975–980; doi:10.14202/vetworld.2020.975-980 Eissa, S., Abdelaziz, E., Hassan, A., Mohamed, Y., Ouda Ahmed, S. and Elshabiny, L. 2024. Molecular detection and characterization of haemoplasmas in different animal species in Egypt. Egypt. J. Vet. Sci. 55, 851–861; doi:10.21608/ejvs.2023.245264.1658 El-gbily, S., Eldokmak, M.M., Diab, R., Abbas, O., Ata, E.B., Kamal, S. and Hassan, S.M.H. 2025. Severe lamb diarrhea outbreak: clinical features, identification of the causative agent, and a prophylactic approach. Comp. Immunol. Microbiol. Infect. Dis. 118, 102318; doi:10.1016/j.cimid.2025.102318 Ge, G., Li, D., Ling, Q., Xu, L., Ata, E.B., Wang, X., Li, K., Hao, W., Gong, Q., Li, J., Shi, K., Leng, X. and Du, R. 2024. IRF7-deficient MDBK cell based on CRISPR/Cas9 technology for enhancing IBRV replication. Front. Microbiol. 15, 1483527; doi:10.3389/fmicb.2024.1483527 Hampel, J.A., Spath, S.N., Bergin, I.L., Lim, A., Bolin, S.R. and Dyson, M.C. 2014. Prevalence and diagnosis of hemotrophic mycoplasma infection in research sheep and its effects on hematology variables and erythrocyte membrane fragility. Comp. Med. 64, 478–485. Hoelzle, K., Winkler, M., Kramer, M.M., Wittenbrink, M.M., Dieckmann, S.M. and Hoelzle, L.E. 2011. Detection of Candidatus mycoplasma haemobos in cattle with anaemia. Vet. J. 187, 408–410; doi:10.1016/j.tvjl.2010.01.016 Ibrahiem, H.S., Alsenosy, A.A., El-Ktany, E.M., Ata, E.B. and Abas, O.M. 2023. Anthelmintic efficacy and pharmcodynamic effects of levamisole oxyclozanide combination as (Levanide®) in fattening calves. Egypt. J. Vet. Sci. 54, 1245–1254; doi:10.21608/EJVS.2023.219811.1532 Kasem, S., Yu, M.H.H., Alkhalefa, N., Ata, E.B., Nayel, M., Abdo, W., Abdel-Moneim, A.S. and Fukushi, H. 2024. Impact of equine herpesvirus-1 ORF15 (EUL45) on viral replication and neurovirulence. Vet. Microbiol. 298, 110234; doi:10.1016/j. vetmic.2024.110234 Kmetiuk, L.B., Shaw, P., Wallington, A., Kattoor, J.J., Johnson, M., Wilkes, R.P., Biondo, L.M., Giuffrida, R., Santarém, V.A., Figueiredo, F.B., Messick, J.B., dos Santos, A.P. and Biondo, A.W. 2025. Hemotropic mycoplasmas (hemoplasmas) in indigenous populations and their dogs living in reservation areas, Brazil. Sci. Rep. 15, 7973; doi:10.1038/s41598-025-87938-0 Machado, C.A.L., Vidotto, O., Conrado, F.O., Santos, N.J.R., Valente, J.D.M., Barbosa, I.C., Trindade, P.W.S., Garcia, J.L., Biondo, A.W., Vieira, T.S.W.J. and Vieira, R.F.C. 2017. Mycoplasma ovis infection in goat farms from northeastern Brazil. Comp. Immunol. Microbiol. Infect. Dis. 55, 1–5; doi:10.1016/j.cimid.2017.08.004 Messick, J.B. 2004. Hemotrophic mycoplasmas (hemoplasmas): a review and new insights into pathogenic potential. Vet. Clin. Pathol. 33, 2–13; doi:10.1111/j.1939-165x.2004.tb00342.x Moore, C.O., Lashnits, E., Lappin, M., Hawley, J. and Breitschwerdt, E.B. 2024. A case of mistaken identity: a systematic review, meta-analysis, and reinvestigation of hemotropic Mycoplasma spp. infection in Ctenocephalides felis (cat flea). Parasit. Vectors 17, 209; doi:10.1186/s13071-024-06292-8 Paul, B.T., Jesse, F.F.A., Chung, E.L.T., Che-Amat, A., Mohd Lila, M.A., Hashi, H.A. and Norsidin, M.J. 2020. Review of clinical aspects, epidemiology and diagnosis of haemotropic Mycoplasma ovis in small ruminants: current status and future perspectives in tropics focusing on Malaysia. Trop. Anim. Health Prod. 52, 2829–2844; doi:10.1007/s11250-020-02357-9 Ravagnan, S., Carli, E., Piseddu, E., Da Rold, G., Porcellato, E., Zanardello, C., Carminato, A., Vascellari, M. and Capelli, G. 2017. Prevalence and molecular characterization of canine and feline hemotropic mycoplasmas (hemoplasmas) in northern Italy. Parasit. Vectors 10, 132; doi:10.1186/ s13071-017-2069-9 Rjeibi, M.R., Darghouth, M.A., Omri, H., Souidi, K., Rekik, M. and Gharbi, M. 2015. First molecular isolation of Mycoplasma ovis from small ruminants in North Africa. Onderstepoort. J. Vet. Res. 82, e1– e6; doi:10.4102/ojvr.v82i1.912 Salman, M.B., Eldin, D.A.S., Ibrahim, A., Zin, A., Shaapan, R.M., Ata, E.B. and Elaadli, H. 2024. Prevalence, virulence determinants and antimicrobial resistance genes of Staphylococcus aureus strains isolated from retail market fish and their handlers in Egypt. Egypt. J. Aquat. Biol. Fish 28, 1101–1118; doi:10.21608/ejabf.2024.339763 Shalaby, H., Kandil, O., Hendawy, S., Elsawy, B.S., Ashry, H.M., El-Namaky, A. and Ata, E.B. 2024. Dynamics of Haemonchus contortus coproantigen appearance in feces of experimentally infected sheep. Egypt. J. Vet. Sci. 55, 1307–1314; doi:10.21608/EJVS.2024.251684.1693 Song, Q., Zhang, W., Song, W., Liu, Z., Khan, M.K., He, L., Fang, R., Li, P., Zhou, Y., Hu, M. and Zhao, J. 2014. Seroprevalence and risk factors of Mycoplasma suis infection in pig farms in central China. Prev. Vet. Med. 117, 215–221; doi:10.1016/j. prevetmed.2014.07.006 Souza, U.A., Oberrather, K., Fagundes-Moreira, R., de Almeida, B.A., de Valle, S.F., Girotto-Soares, A. and Soares, J.F., 2019. First molecular detection of Mycoplasma ovis (Hemotropic mycoplasmas) from sheep in Brazil. Rev. Bras. Parasitol. Vet. 28, 360– 366; doi:10.1590/s1984-29612019022 Stuen, S. 2016. Haemoparasites in small ruminants in European countries: challenges and clinical relevance. Small Rumin. Res. 142, 22–27; doi:10.1016/j.smallrumres.2016.03.005 Suzuki, J., Sasaoka, F., Fujihara, M., Watanabe, Y., Tasaki, T., Oda, S., Kobayashi, S., Sato, R., Nagai, K. and Harasawa, R. 2011. Molecular identification of “Candidatus mycoplasma haemovis” in sheep with hemolytic anemia. J. Vet. Med. Sci. 73, 1113– 1115; doi:10.1292/jvms.11-0113 Tagawa, M., Takeuchi, T., Fujisawa, T., Konno, Y., Yamamoto, S., Matsumoto, K., Yokoyama, N. and Inokuma, H. 2012. A clinical case of severe anemia in a sheep coinfected with Mycoplasma ovis and Candidatus mycoplasma haemovis’ in Hokkaido, Japan. J. Vet. Med. Sci. 74, 99–102; doi:10.1292/ jvms.11-0296 Tanahara, M., Miyamoto, S., Nishio, T., Yoshii, Y., Sakuma, M., Sakata, Y., Nishigaki, K., Tsujimoto, H., Setoguchi, A. and Endo, Y. 2010. An epidemiological survey of feline hemoplasma infection in Japan. J. Vet. Med. Sci. 72, 1575–1581; doi:10.1292/jvms.10-0143 Tasker, S. 2020. Hemotropic Mycoplasma. In Clinical small animal internal medicine. Eds. Bruyette, D.S., Bexfield, N., Chretin, J.D., Kidd, L., Kube, S., Langston, C., Owen, T.J., Oyama, M.A., Peterson, N., Reiter, L.V., Rozanski, E.A., Ruaux, C. and Torres, S.M.F. Wiley-Blackwell, pp: 927–930; doi:10.1002/9781119501237.ch97 Urie, N.J., Highland, M.A., Knowles, D.P., Branan, M.A., Herndon, D.R. and Marshall, K.L. 2019. Mycoplasma ovis infection in domestic sheep (Ovis aries) in the United States: prevalence, distribution, associated risk factors, and associated outcomes. Prev. Vet. Med. 171, 104750; doi:10.1016/j. prevetmed.2019.104750 Wang, X., Cui, Y., Zhang, Y., Shi, K., Yan, Y., Jian, F., Zhang, L., Wang, R. and Ning, C. 2017. Molecular characterization of hemotropic mycoplasmas (Mycoplasma ovis and ‘Candidatus mycoplasma haemovis’) in sheep and goats in China. BMC Vet. Res. 13, 142; doi:10.1186/s12917-017-1062-z Willi, B., Boretti, F.S., Baumgartner, C., Tasker, S., Wenger, B., Cattori, V., Meli, M.L., Reusch, C.E., Lutz, H. and Hofmann-Lehmann, R. 2006. Prevalence, risk factor analysis, and follow-up of infections caused by three feline hemoplasma species in cats in Switzerland. J. Clin. Microbiol. 44, 961–969; doi:10.1128/JCM.44.3.961-969.2006 Zachary, J. 2017. Pathologic basis of veterinary disease, 6th ed. Elsevier. | ||
| How to Cite this Article |
| Pubmed Style Ouda SE, Hassan RA, Ismaeel ES, Abo-sakaya R, Ata EB, Sedky D, Kandil MM, Shabiny LME. Molecular diagnosis of hemoplasma infection in cats and sheep with hematological studies. Open Vet. J.. 2025; 15(6): 2823-2830. doi:10.5455/OVJ.2025.v15.i6.51 Web Style Ouda SE, Hassan RA, Ismaeel ES, Abo-sakaya R, Ata EB, Sedky D, Kandil MM, Shabiny LME. Molecular diagnosis of hemoplasma infection in cats and sheep with hematological studies. https://www.openveterinaryjournal.com/?mno=254478 [Access: January 26, 2026]. doi:10.5455/OVJ.2025.v15.i6.51 AMA (American Medical Association) Style Ouda SE, Hassan RA, Ismaeel ES, Abo-sakaya R, Ata EB, Sedky D, Kandil MM, Shabiny LME. Molecular diagnosis of hemoplasma infection in cats and sheep with hematological studies. Open Vet. J.. 2025; 15(6): 2823-2830. doi:10.5455/OVJ.2025.v15.i6.51 Vancouver/ICMJE Style Ouda SE, Hassan RA, Ismaeel ES, Abo-sakaya R, Ata EB, Sedky D, Kandil MM, Shabiny LME. Molecular diagnosis of hemoplasma infection in cats and sheep with hematological studies. Open Vet. J.. (2025), [cited January 26, 2026]; 15(6): 2823-2830. doi:10.5455/OVJ.2025.v15.i6.51 Harvard Style Ouda, S. E., Hassan, . R. A., Ismaeel, . E. S., Abo-sakaya, . R., Ata, . E. B., Sedky, . D., Kandil, . M. M. & Shabiny, . L. M. E. (2025) Molecular diagnosis of hemoplasma infection in cats and sheep with hematological studies. Open Vet. J., 15 (6), 2823-2830. doi:10.5455/OVJ.2025.v15.i6.51 Turabian Style Ouda, Sahar E., Randa A. Hassan, Eissa S. Ismaeel, Rania Abo-sakaya, Emad Beshir Ata, Doaa Sedky, Mai M. Kandil, and Laila M. El Shabiny. 2025. Molecular diagnosis of hemoplasma infection in cats and sheep with hematological studies. Open Veterinary Journal, 15 (6), 2823-2830. doi:10.5455/OVJ.2025.v15.i6.51 Chicago Style Ouda, Sahar E., Randa A. Hassan, Eissa S. Ismaeel, Rania Abo-sakaya, Emad Beshir Ata, Doaa Sedky, Mai M. Kandil, and Laila M. El Shabiny. "Molecular diagnosis of hemoplasma infection in cats and sheep with hematological studies." Open Veterinary Journal 15 (2025), 2823-2830. doi:10.5455/OVJ.2025.v15.i6.51 MLA (The Modern Language Association) Style Ouda, Sahar E., Randa A. Hassan, Eissa S. Ismaeel, Rania Abo-sakaya, Emad Beshir Ata, Doaa Sedky, Mai M. Kandil, and Laila M. El Shabiny. "Molecular diagnosis of hemoplasma infection in cats and sheep with hematological studies." Open Veterinary Journal 15.6 (2025), 2823-2830. Print. doi:10.5455/OVJ.2025.v15.i6.51 APA (American Psychological Association) Style Ouda, S. E., Hassan, . R. A., Ismaeel, . E. S., Abo-sakaya, . R., Ata, . E. B., Sedky, . D., Kandil, . M. M. & Shabiny, . L. M. E. (2025) Molecular diagnosis of hemoplasma infection in cats and sheep with hematological studies. Open Veterinary Journal, 15 (6), 2823-2830. doi:10.5455/OVJ.2025.v15.i6.51 |